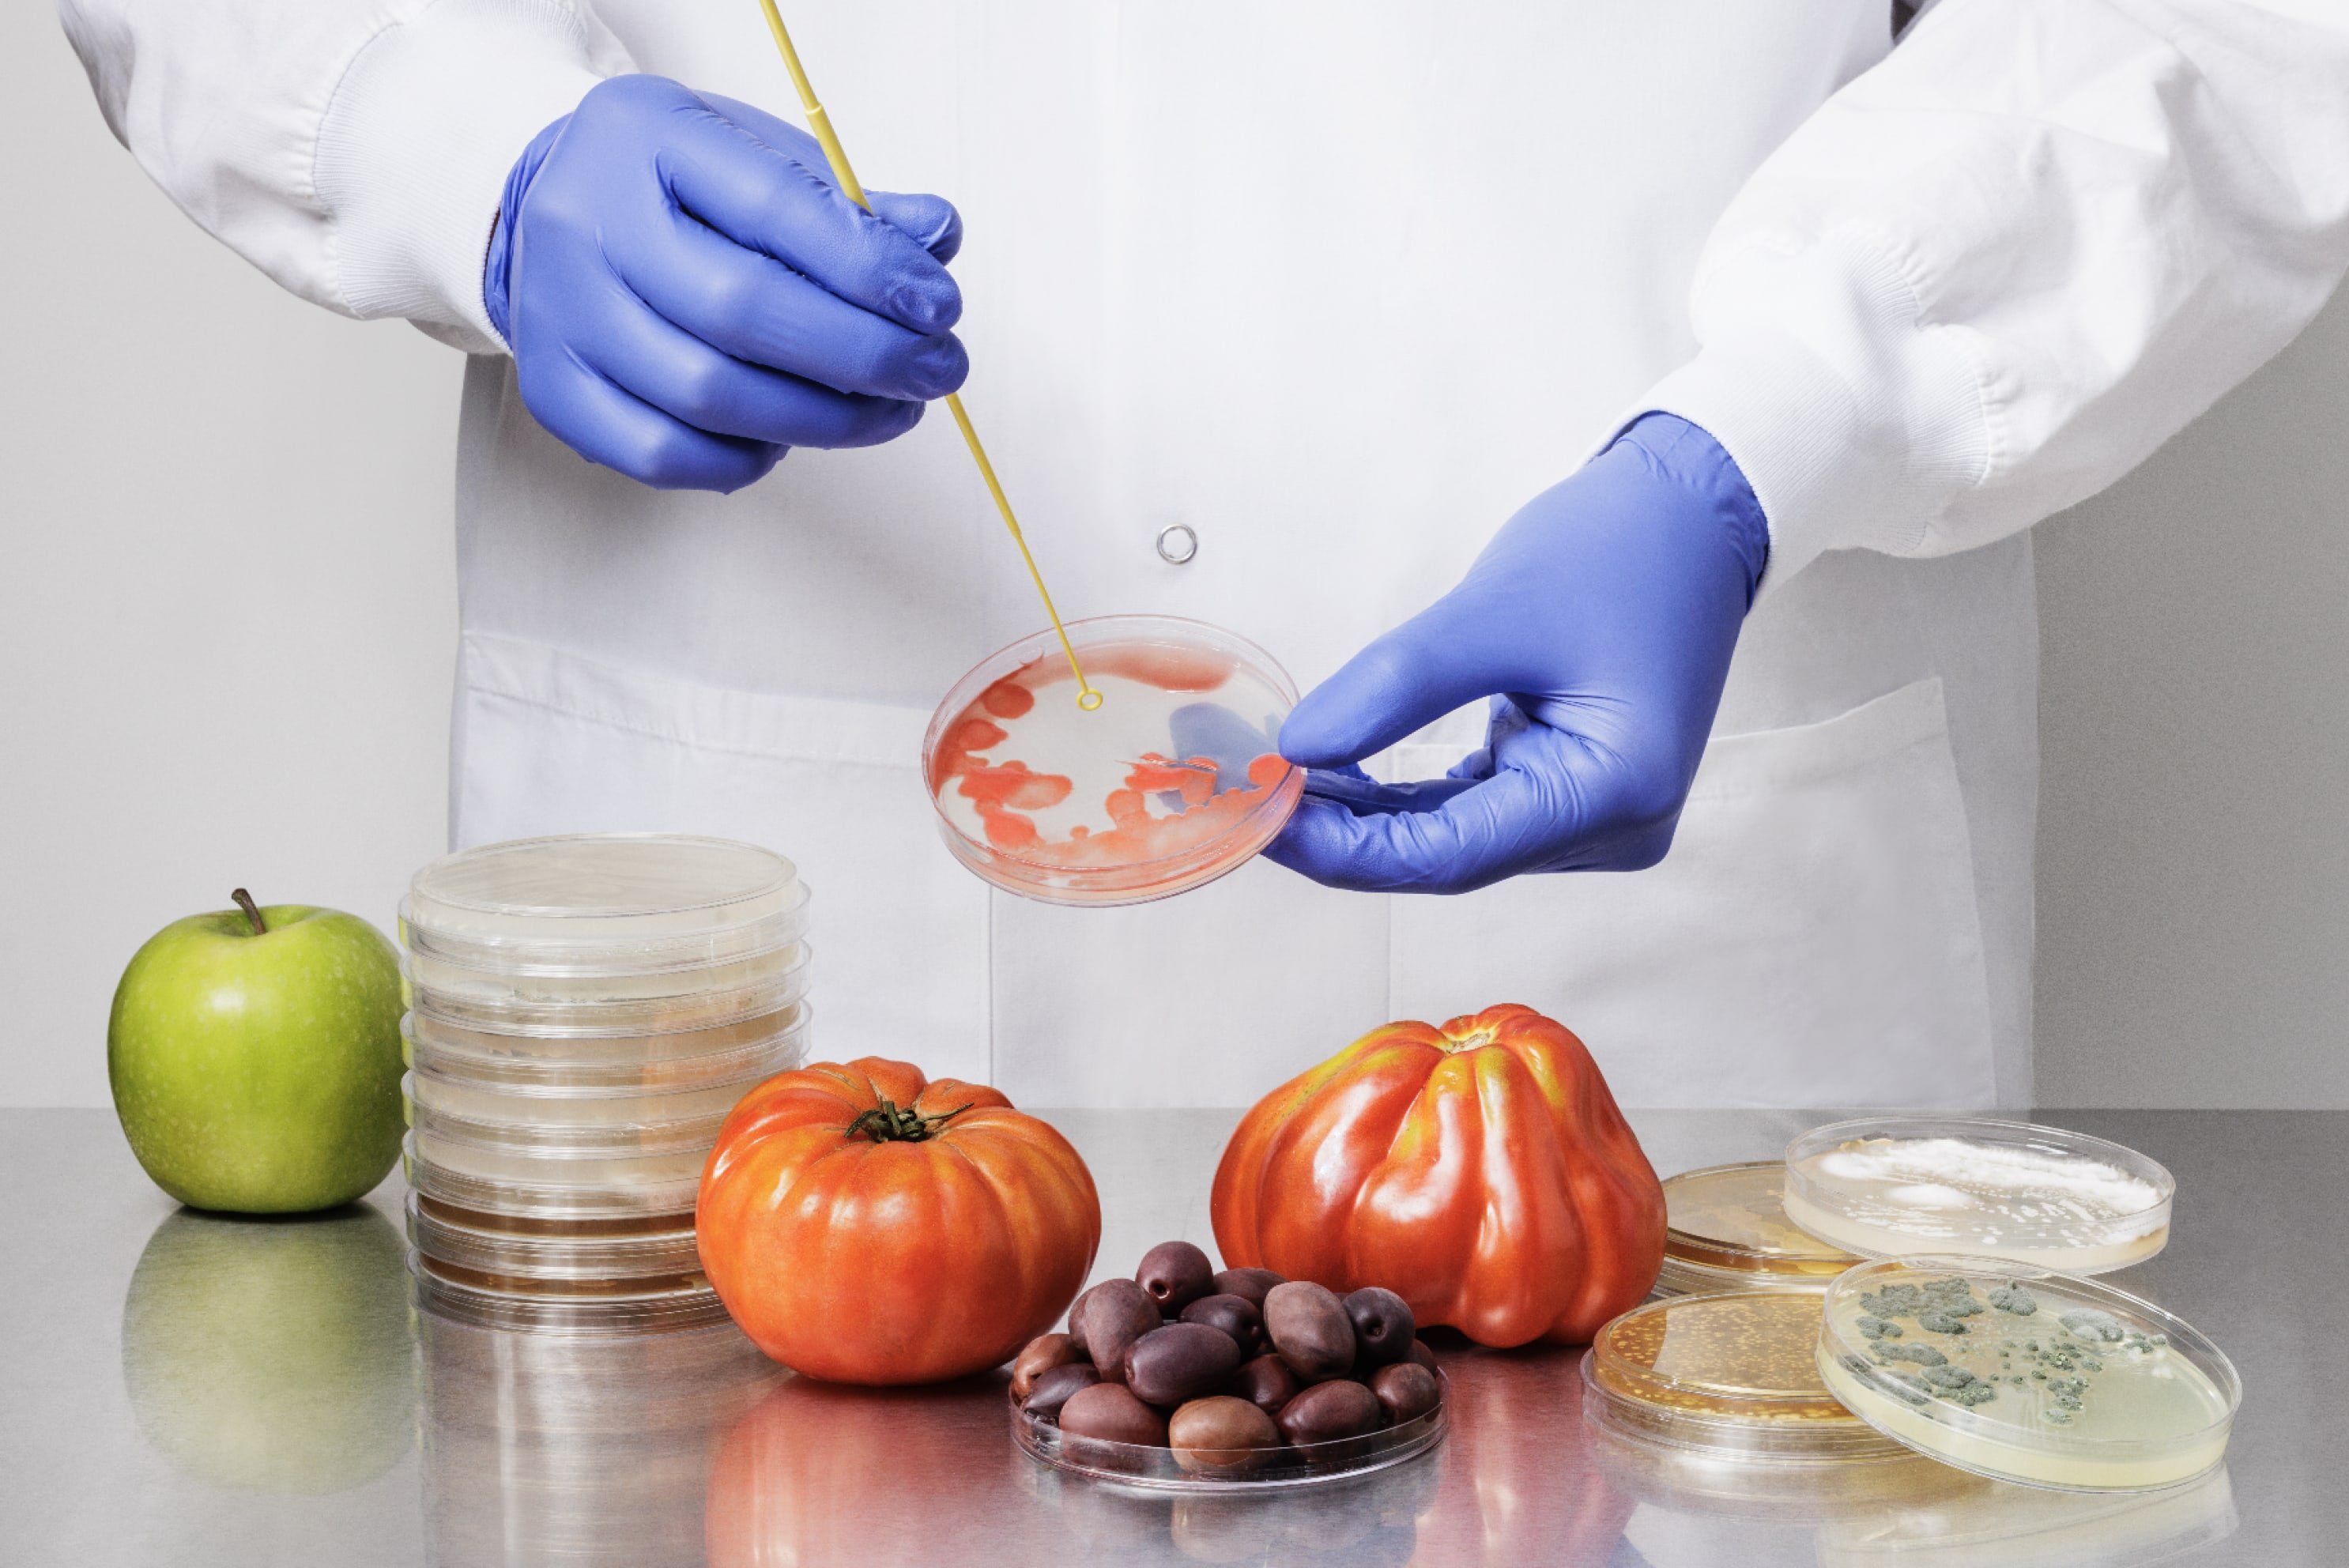

Brandbuilder
















FULL BRAND LAUNCH












FULL BRAND LAUNCH












Rebrand
















Full brand launch








Rebrand












Full brand launch












FULL BRAND LAUNCH

FULL BRAND LAUNCH

















Incubated branding

















Rebrand

New brands. Rebrands. In Practice.
I built Practice to expand my approach to brand building. Backed by a small team, we lead holistic brand launches, rebrands, and strategic campaigns that help bring new brands to market and strengthen the equity of existing ones. Our work is built to scale quickly without compromising quality or vision.
New brands. Rebrands. In Practice.

I built Practice to expand my approach to brand building. Backed by a small team, we lead holistic brand launches, rebrands, and strategic campaigns that help bring new brands to market and strengthen the equity of existing ones. Our work is built to scale quickly without compromising quality or vision.















